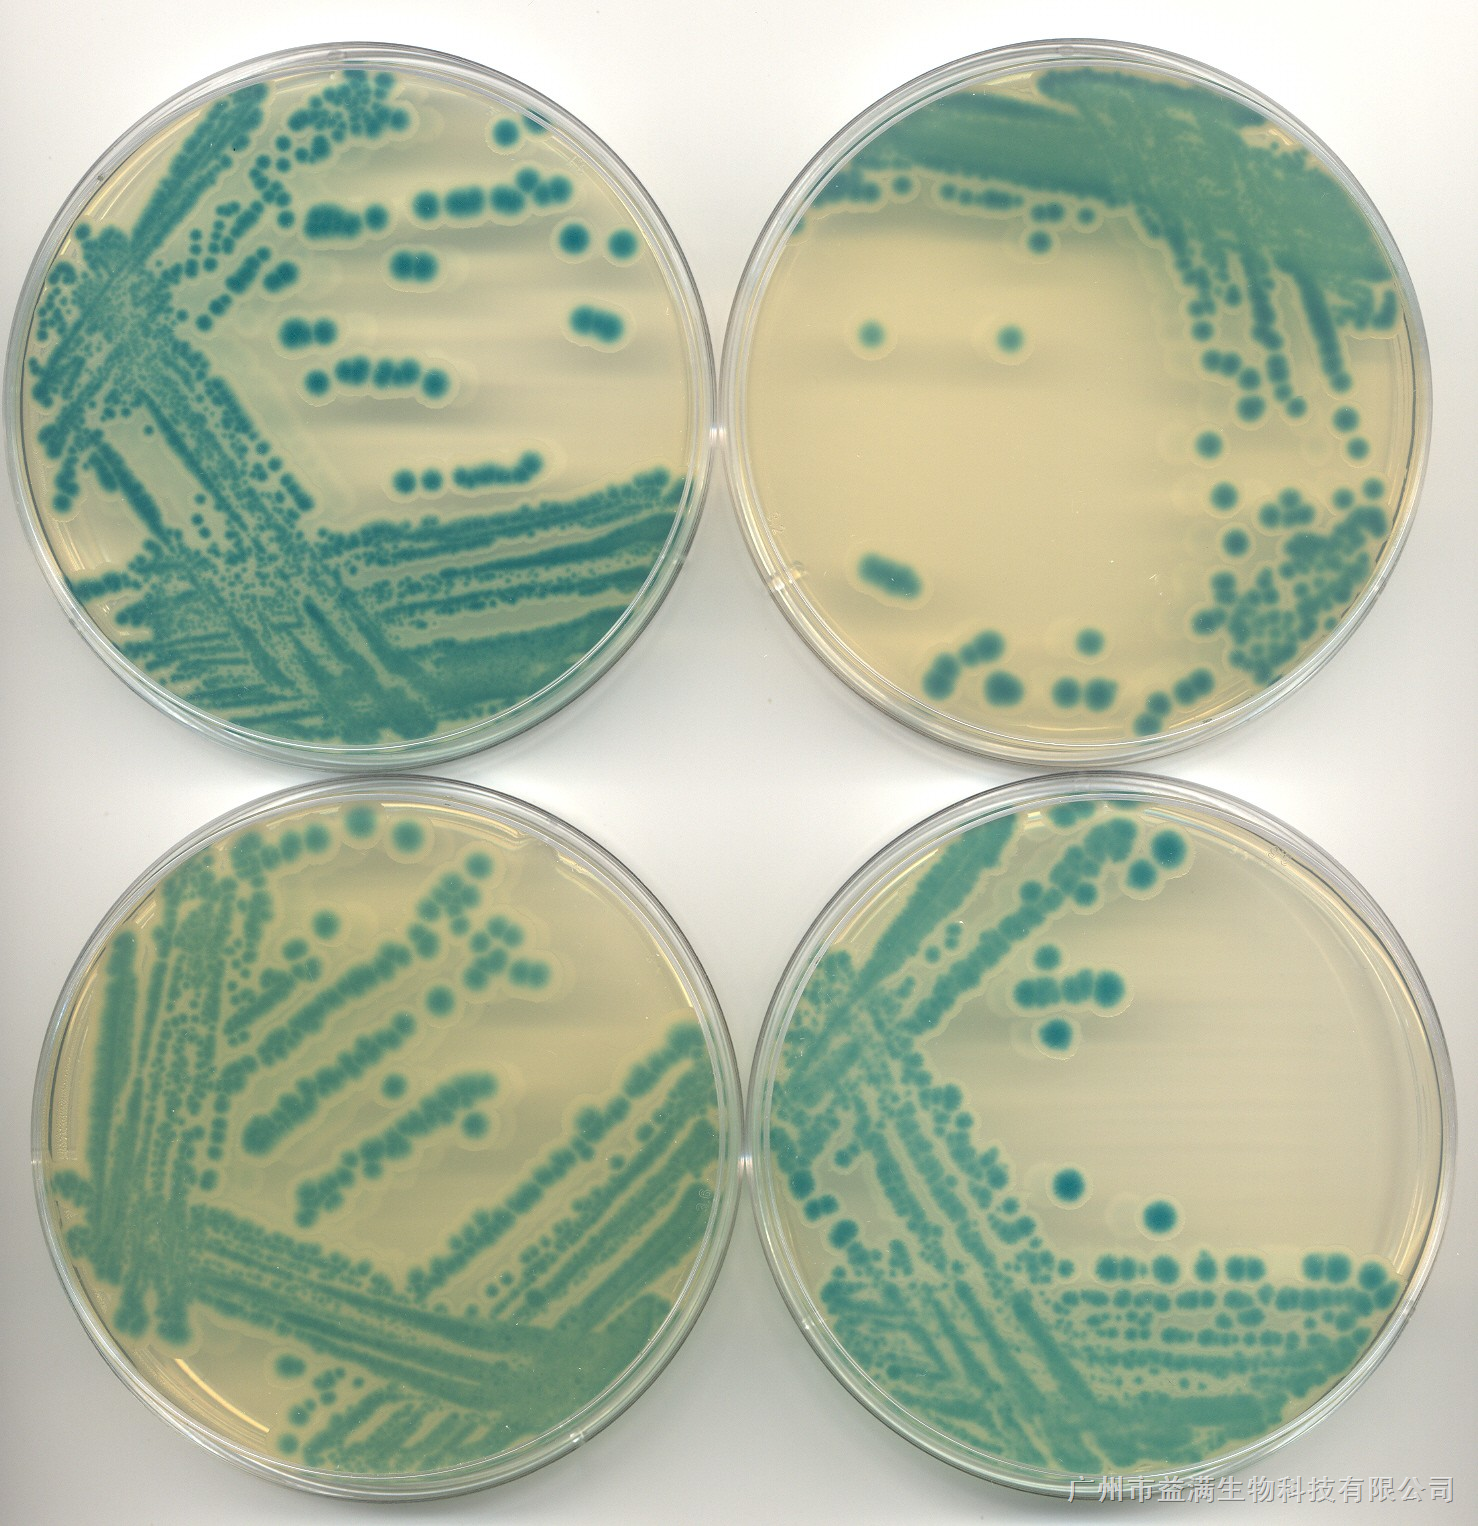
">高氏 /a>一号 a target="_blank" href="/item/培养基/1317328"
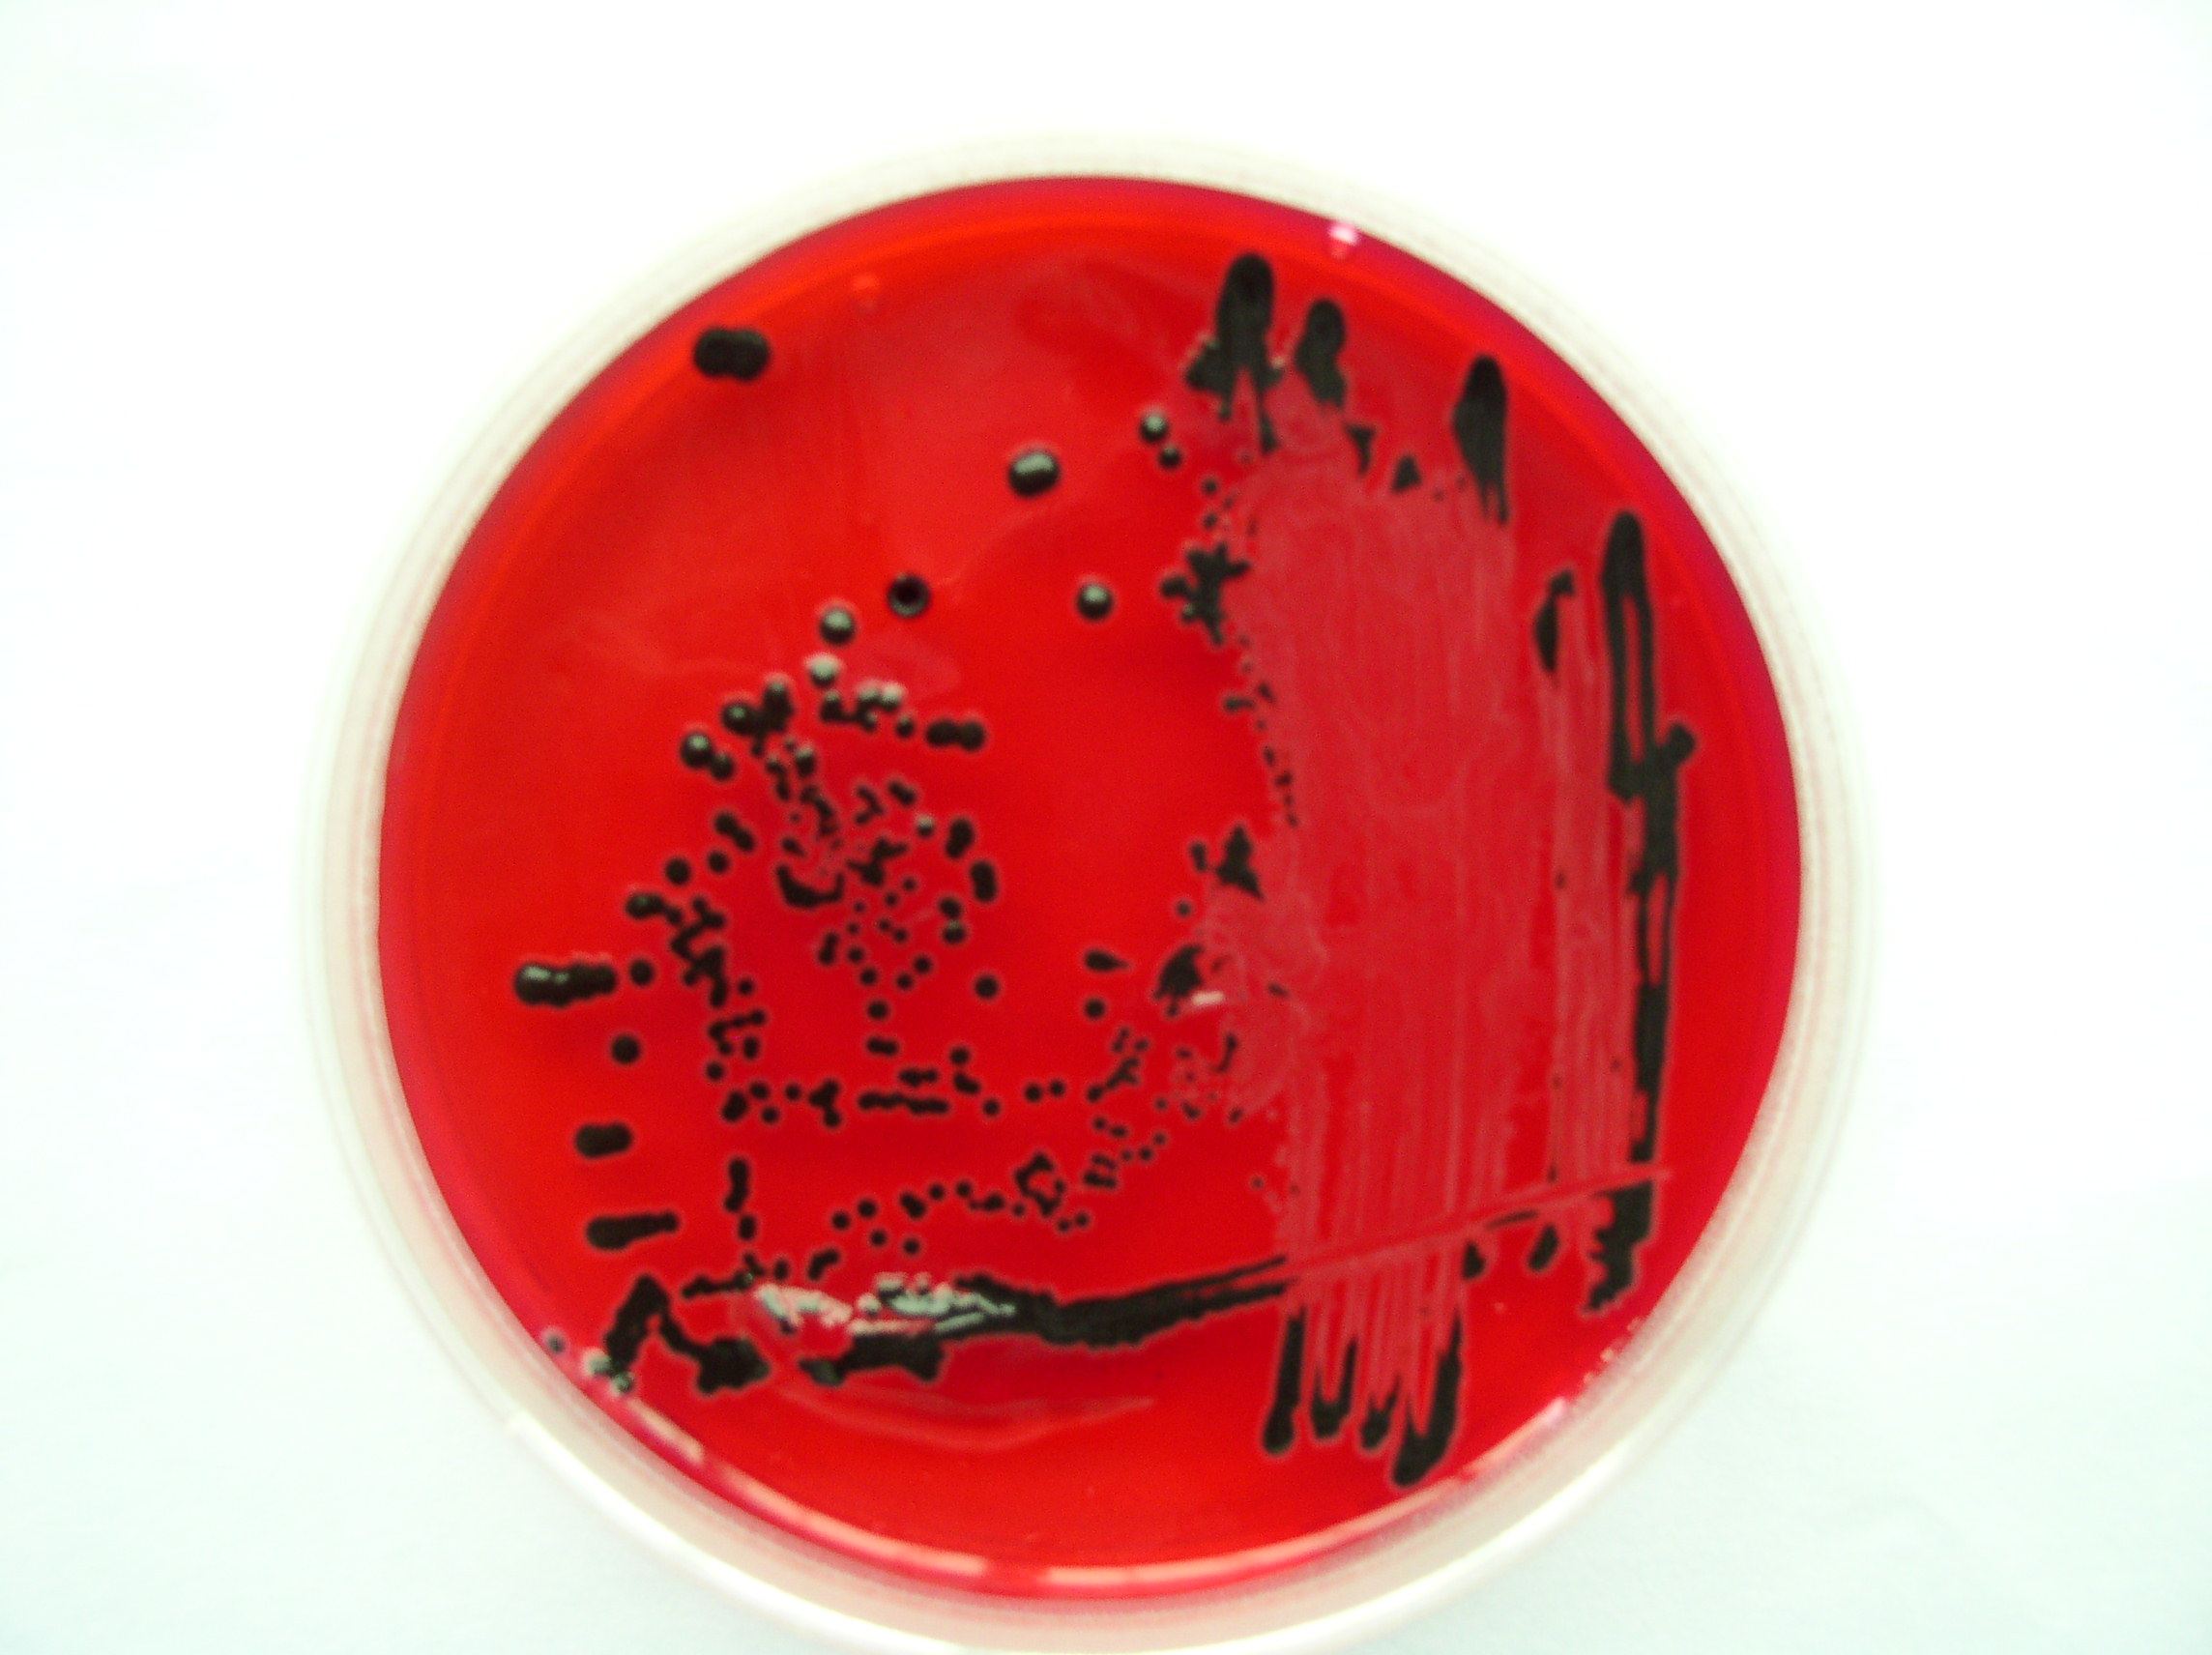
">高氏 /a>一号 a target="_blank" href="/item/培养基/1317328"
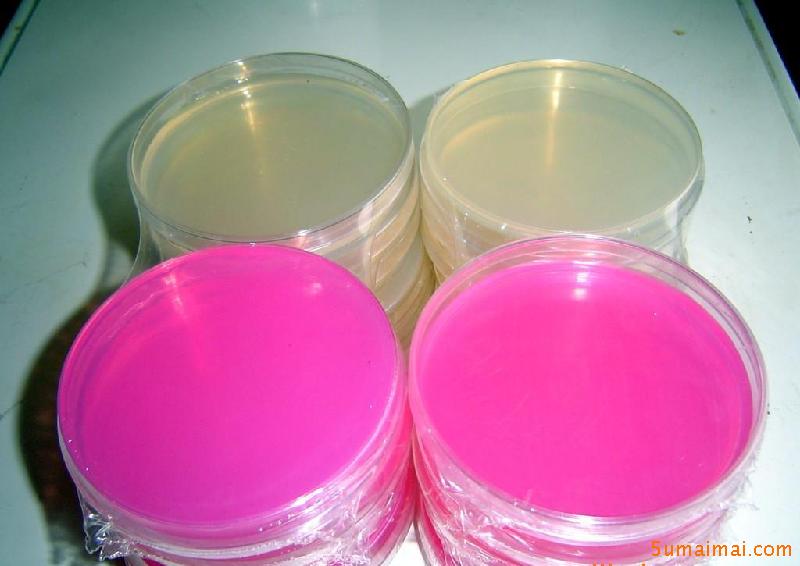
">高氏 /a>一号 a target="_blank" href="/item/培养基/1317328"

高氏一号培养基

">高氏 /a>一号 a target="_blank" href="/item/培养基/1317328"
图片尺寸3264x2448
高氏1号培养基|4|40
图片尺寸220x165
放线菌培养基 改良高氏一号 改良高氏1号 250g 北京陆桥 青岛海博
图片尺寸790x1312
高氏1号培养基
图片尺寸518x563
">高氏 /a>一号 a target="_blank" href="/item/培养基/1317328"
图片尺寸1000x1200
放线菌培养基 改良高氏一号 改良高氏1号 250g 北京陆桥 青岛海博
图片尺寸790x1354
">高氏 /a>一号 a target="_blank" href="/item/培养基/1317328"
图片尺寸1478x1526
放线菌培养基 改良高氏一号 1号 250g hb8550青岛海博
图片尺寸800x800
">高氏 /a>一号 a target="_blank" href="/item/培养基/1317328"
图片尺寸1200x1600
北京陆桥青岛海博放线菌培养基改良高氏一号改良高氏1号250g
图片尺寸300x300
">高氏 /a>一号 a target="_blank" href="/item/培养基/1317328"
图片尺寸2288x1712
上海博微 高氏一号培养基 生化试剂用于筛选培养放线菌250g瓶包邮
图片尺寸800x800
放线菌培养基 改良高氏一号 改良高氏1号 250g 北京陆桥 青岛海博
图片尺寸790x853
">高氏 /a>一号 a target="_blank" href="/item/培养基/1317328"
图片尺寸3264x2448
北京陆桥青岛海博放线菌培养基改良高氏一号改良高氏1号250g
图片尺寸750x1462
">高氏 /a>一号 a target="_blank" href="/item/培养基/1317328"
图片尺寸3264x2448
厂家直销
图片尺寸1200x1600
肠道菌增菌肉汤
图片尺寸1278x1278
">高氏 /a>一号 a target="_blank" href="/item/培养基/1317328"
图片尺寸2556x1504
">高氏 /a>一号 a target="_blank" href="/item/培养基/1317328"
图片尺寸800x566